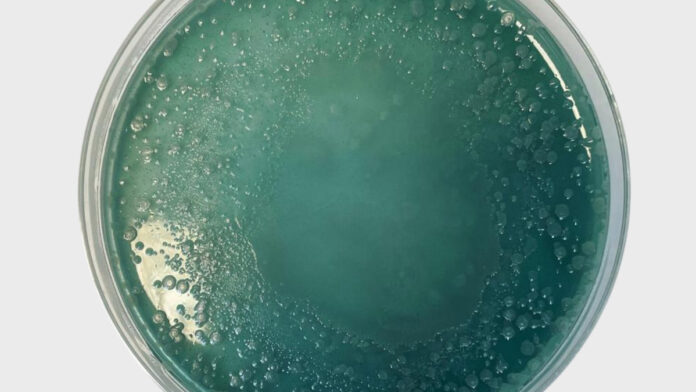
ke_2026_06_109

Kontrola sanepidu to jeden z tych momentów, który u właścicieli salonów beauty potrafi wywołać przyspieszone bicie serca. Niezależnie od tego, czy mowa o gabinecie kosmetologii estetycznej, salonie rzęs, brwi, fryzjerskim, tatuażu, PMU czy makijażu, pojawienie się inspektora często kojarzy się z ryzykiem, stresem i obawą przed ewentualnymi nieprawidłowościami. Tymczasem w praktyce dobrze przygotowany salon nie ma powodów do niepokoju – wręcz przeciwnie. Dla wielu profesjonalnych gabinetów kontrola staje się potwierdzeniem jakości usług oraz realnej troski o bezpieczeństwo klientów.
Julia Brylak
mikrobiolog, ekspert higieny z 14-letnim doświadczeniem, audytorka i edukatorka branży beauty
Pełna wersja artykułu: Kosmetologia Estetyczna. 2025;14(6):109-113
Inne wydania KE w wersji drukowanej lub cyfrowej dostępne w sklepie KE
Kosmetologię Estetyczną kupisz również w sieci Empik